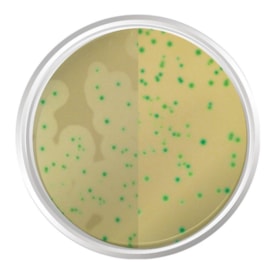
Product image

Olá seja bem-vindo, visitante

ou 10x de R$ 259,71 no cartão de crédito

ou 10x de R$ 574,62 no cartão de crédito

ou 10x de R$ 411,32 no cartão de crédito
ou 10x de R$ 151,00 no cartão de crédito

ou 10x de R$ 1.147,83 no cartão de crédito
Facilite suas identificações! Descubra os cromogênicos desidratados da Loja Netlab. Precisão e praticidade. Adquira já!
SIGA-NOS
@lojanetlab